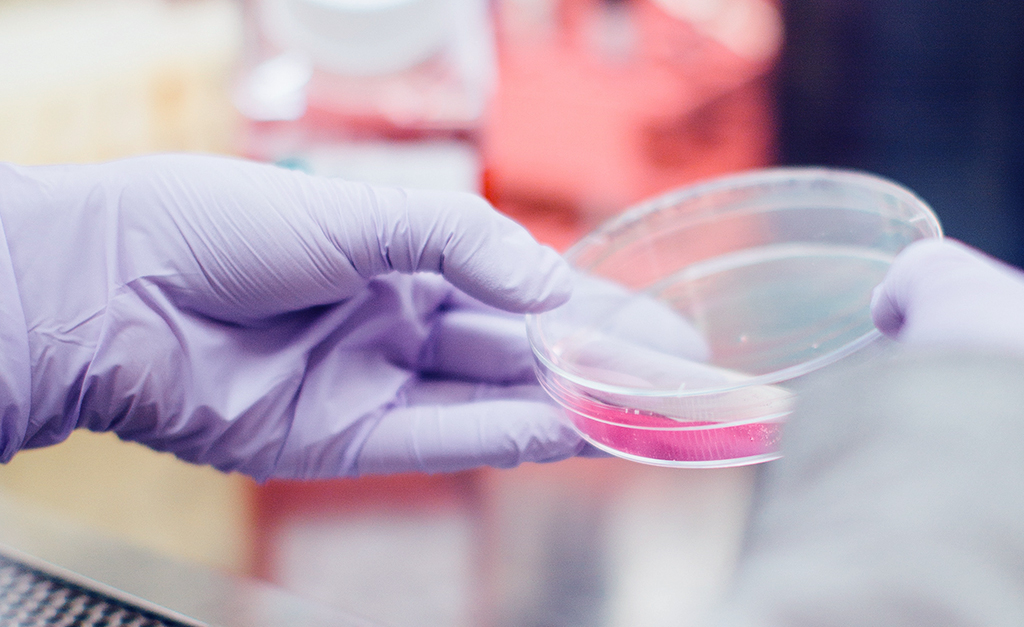

Blogs
Enter Search Inquiries Below
Case Studies
All Blogs



According to the Society for Human Resource Management (SHRM), “[No] company, small or large, can wi...

Enter Search Inquiries Below
According to the Society for Human Resource Management (SHRM), “[No] company, small or large, can wi...